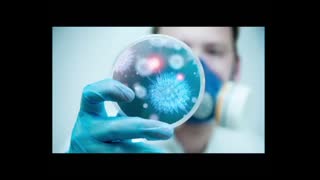
Wzorst liczby zgonów po szczepionkach

Dr. Martin dramatyczna sytuacja po szczepionkach mRNA
16 wyświetlenia
12 dni temu
Dr. Martin dramatyczna sytuacja po szczepionkach mRNA Jeśli szukasz miejsca, gdzie możesz swobodnie pisać, dzielić się swoimi przemyśleniami.
Link do strony https://mystery-network.com/
Chcesz prowadzić otwarte dyskusje bez cenzury — Mystery Network to przestrzeń właśnie dla Ciebie. To platforma stworzona z myślą o wolności słowa, wymianie informacji i budowaniu społeczności ludzi, którzy chcą zadawać pytania i szukać własnych odpowiedzi.
Z kolei Mistrz Foliarstwa pełni inną rolę — to archiwum materiałów wideo, miejsce, gdzie gromadzone są treści i nagrania. Nie ma tam możliwości rejestracji ani aktywnego udziału w dyskusjach.
Dlatego jeśli chcesz być częścią rozmowy, komentować, analizować i współtworzyć społeczność — kierunek jest jeden: Mystery Network.
Udostępnij Wideo
Dodaj do
Proszę Zaloguj się lub Utwórz konto aby użyć tej funkcji!
Zgłoś Wideo
Proszę Zaloguj się lub Utwórz konto aby użyć tej funkcji!
Oceń wideo
Proszę Zaloguj się lub Utwórz konto aby użyć tej funkcji!
Oceń wideo
Proszę Zaloguj się lub Utwórz konto aby użyć tej funkcji!
Obserwuj
Proszę Zaloguj się lub Utwórz konto aby użyć tej funkcji!
Subskrybuj
Proszę Zaloguj się lub Utwórz konto aby użyć tej funkcji!
Następne
Autoodtwarzanie
Autoodtwarzanie
Polecane
-
Obejrzyj później
 04:04
04:04Dramatyczna sytuacja na świecie po szczepieniu
MF7778 wyświetlenia 12 dni temu -
Obejrzyj później
 03:43
03:43Ataki cybernetyczne po ujawnieniu prawdy o mRNA
MF777183 wyświetlenia 16 dni temu -
Obejrzyj później
 04:31
04:31mRNA kontrowersje – bezpieczeństwo technologii i pytania, które wciąż powracają
MF777227 wyświetlenia 16 dni temu -
Obejrzyj później
 01:22
01:22Skład szczepionek mRNA – co zawierają i jakie są kontrowersje
MF77741 wyświetlenia 16 dni temu -
Obejrzyj później
 01:13
01:13Wstępne raporty po szczepieniach analiza zgłaszanych objawów mRNA
MF77728 wyświetlenia 14 dni temu